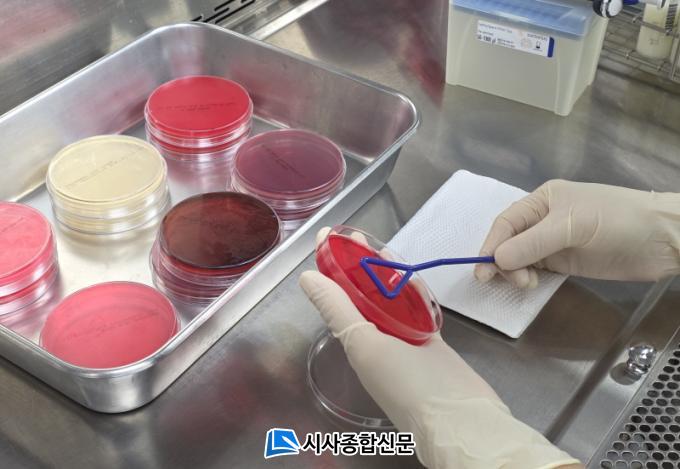

Ȥ¼±â¿¡´Â Á÷»ç±¤¼±À» ÇÇÇϵµ·Ï Ãà»ç¿¡ ±×´Ã¸·À» ¼³Ä¡Çϰí, Á¥¼ÒÀÇ Ã¼¿À» »¡¸® ¹èÃâÇϵµ·Ï ¼Ûdz±â¿Í ȯ±â½Ã¼³À» °®Ãç¾ß ÇÑ´Ù. ÀÌ¿Í ÇÔ²² Á¥¼Ò°¡ ÃæºÐÇÑ ¼öºÐÀ» ¼·ÃëÇϵµ·Ï ½Ã¿øÇÑ ¹°À» ¼ö½Ã·Î °ø±ÞÇϰí, »ç·á¿¡ ´Ü¹éÁú°ú ºñŸ¹Î º¸ÃæÁ¦¸¦ Ãß°¡ÇØ ¿µ¾ç ±ÕÇüÀ» ¸ÂÃç¾ß Çϸç, ¾çÁúÀÇ Á¶»ç·á¸¦ ÀûÀýÈ÷ °ø±ÞÇØ »ç·á ¼·Ãë·® °¨¼Ò¸¦ ¹æÁöÇØ¾ß ÇÑ´Ù.
°í¿Â°ú ³ôÀº ½Àµµ·Î º´¿ø¼º ¹Ì»ý¹°ÀÌ ¹ø½ÄÇϱ⠽¬¿ì¹Ç·Î Ãà»ç ³»¿Ü¸¦ ÁÖ±âÀûÀ¸·Î û¼Ò¡¤¼Òµ¶Çϰí ÇØÃæ ¹æÁ¦µµ ÇØ¾ß ÇÑ´Ù. ÂøÀ¯ À§»ý ¿ª½Ã ¸Å¿ì Áß¿äÇϹǷÎ, ÂøÀ¯ Àü À¯¹æÀ» ¼¼Ã´ÇÑ µÚ ¸¶¸¥ ¼ö°ÇÀ¸·Î ¹°±â¸¦ Á¦°ÅÇϰí, ÂøÀ¯ ÈÄ¿¡µµ À¯µÎ¸¦ ±ú²ýÀÌ ´Û¾Æ ¿ÏÀüÈ÷ °ÇÁ¶½ÃŰ´Â À§»ý °ü¸®°¡ ¿ä±¸µÈ´Ù.
Á¤Áö¿µ Àü³²µµµ¿¹°À§»ý½ÃÇè¼ÒÀåÀº ¡°Á¥¼Ò´Â 4¡É¿¡¼ 20¡É »çÀÌ ¿Âµµ¿¡¼ °¡Àå Æí¾ÈÇÏ°Ô »ýȰÇÒ ¼ö Àֱ⠶§¹®¿¡, ¿©¸§Ã¶¿¡´Â Ãà»ç ¿Âµµ¸¦ ³·Ãß´Â ³ë·ÂÀÌ ÇÊ¿äÇÏ´Ù¡±¸ç ¡°³ó°¡¿¡¼´Â Ãà»ç¸¦ û°áÇÏ°Ô À¯ÁöÇϰí, ÇØÃæ ¹æÁ¦¿Í ¼Òµ¶À» ÁÖ 1ȸ ÀÌ»ó Á¤±âÀûÀ¸·Î ½Ç½ÃÇÏ´Â µî ¿©¸§Ã¶ Áúº´ ¿¹¹æ°ú ¿øÀ¯ ǰÁú Çâ»ó¿¡ Èû½á´Þ¶ó¡±°í ´çºÎÇß´Ù.


2026.03.24 (È) 17:25